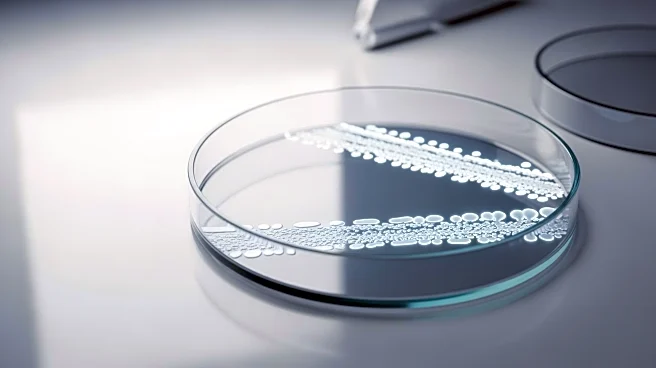
New Assay Developed for Detecting Campylobacter in Chicken Meat

What's Happening?
Researchers have developed a chromogenic assay for detecting hippuricase-positive bacteria, specifically Campylobacter jejuni, in raw chicken meat samples. The assay utilizes the hippuricase enzyme to
convert 4-hydroxyhippuric acid to hydroxybenzoic acid and glycine, which is then oxidized to produce a pink dye. This method allows for rapid detection of C. jejuni, a common cause of gastroenteritis, by indicating positive samples through color change. The assay has been validated with various bacterial strains and demonstrates high sensitivity, offering a promising tool for food safety testing.
Why It's Important?
The development of this chromogenic assay is significant for food safety, particularly in the poultry industry, where Campylobacter infections are prevalent. By providing a rapid and sensitive detection method, the assay can help prevent the spread of gastroenteritis caused by contaminated chicken meat. This innovation may lead to improved monitoring and control measures in food processing facilities, reducing the risk of outbreaks and enhancing consumer safety. Additionally, the assay's ability to detect low bacterial concentrations could support regulatory compliance and quality assurance efforts in the food industry.